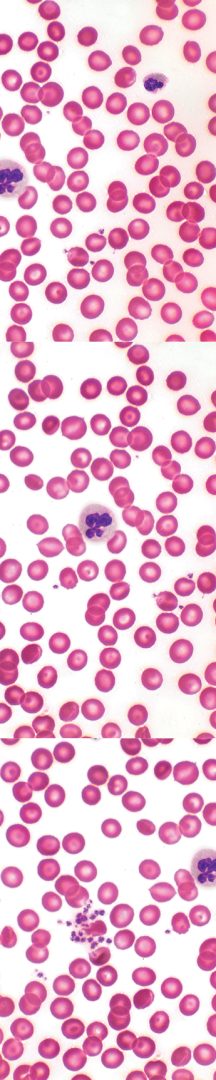

CKSci Unit 5: Human Cells and Digestion
Focus:
In this unit, students will trace the path of the digestive system starting with hunger and the purpose of eating food. Students will explore the digestive system and its different parts, understanding the hierarchy of cells, tissues, organs, and organ systems. Students will also look at the building blocks of the body: cells. Students will end with identifying how waste leaves the body and investigating the nutritional needs of our bodies as well.
Students know they get hungry, they eat food, and they use the restroom. What students may not understand is how their bodies engage in those processes. What enables students’ bodies to break that food down to get nutrients and energy? Students may not know that energy, in the form of chemicals that make up food, goes to cells in the body so the cells can carry out all the functions people need to live. During the process of breaking down food, not all energy can be used, so it needs to be eliminated as waste. The digestive system is one of the systems in the body that eliminates waste.
In this unit, students investigate the human digestive system to identify how our bodies use food for energy. Students will further investigate living things’ need for food in Grade 5 Unit 2 Energy and Matter in Ecosystems.
Students explore concepts that include the following:
- Identify and describe parts of the digestive system.
- Summarize the functions of the digestive system.
- Explain the purpose of eating and digesting food as fueling the body’s cells.
- Describe cells of different types.
- Identify and describe parts of the body involved in waste elimination.
- Summarize the functions of the excretory system.
- Summarize waste elimination in the digestive system.
- Discuss health practices regarding nutrition and vaccines.
Number of Lessons: 7
Instruction Time:
- Because this unit is not designed to support any specific NGSS Performance Expectation, the instructional episodes are not grouped into multipart lessons. As such, they are identified simply as lessons instead of lesson segments.
- Each Lesson is designed to be completed in one 30–45-minute class period.
- Some single-day activities and performance tasks might require setting aside a longer block of time.
- This Unit should be completed in about 30 classroom days.
- A Pacing Guide Template is usually provided within the Teacher Guide so teachers can map out customized instructional days for this unit.
- A complete list of Materials needed to complete the unit is provided in Online Resources.
Additional Search Terms:
hungry • hunger • food • digestion • stomach • small intestine • large intestine • cell • tissue • organ • organ system • body waste • urine • health • healthy • nutrition • nonfiction • informational text



